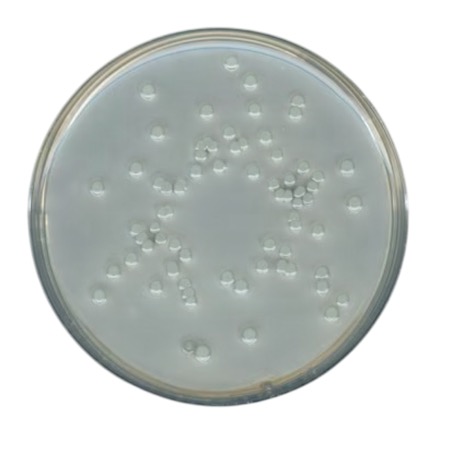

Granulated Plate Count Agar (GranuCult prime) is a non-selective culture medium for total aerobic bacteria enumeration in food, beverage, water and related microbiological quality control applications conforming to ISO 4833, ISO 17410, IFU and FDA-BAM standards.
Plate Count Agar, catalogue No. 105463, is a high-quality granular microbiological culture medium supplied by MilliporeSigma / Merck under the GranuCult® prime designation. It is formulated for total aerobic bacterial enumeration according to internationally recognized methods including ISO 4833, ISO 17410, IFU and FDA-BAM. Also known as Aerobic Plate Count Agar or Casein-Peptone Dextrose Yeast Agar, this medium contains enzymatic digest of casein (tryptone), yeast extract and glucose to provide a nutrient-rich environment that supports growth of a wide range of aerobic bacteria. The granular form ensures reliable dissolution and consistent medium performance for routine microbiological quality control in food, beverage, water and environmental testing laboratories.
Advantages
- Suitable for total aerobic bacterial enumeration in microbiological quality control.
- Complies with international standards ISO 4833, ISO 17410, IFU and FDA-BAM.
- GranuCult® prime quality for consistent performance and regulatory compliance.
- Granulated dehydrated medium allows flexible preparation of plates or broths.
- Non-selective formulation supports a broad spectrum of aerobic bacteria.
- Applicable across food, beverage, dairy, water and environmental laboratories.
Technical specifications
| Product name | Plate Count agar |
| Catalogue number | 105463 |
| Brand / quality | GranuCult® prime |
| Form | Granulated dehydrated medium |
| Compliance standards | ISO 4833, ISO 17410, IFU, FDA-BAM |
| Technique | Microbiological culture / total aerobic count |
| Suitable for | Aerobic bacteria (total count) |
| Typical use | Food, beverage, dairy, water and environmental microbiology QC |
| Prepared pH | ~7.0 (30 °C, 22 g/L after autoclaving) |
| Solubility | 22.5 g/L |
| Bulk density | ~560 kg/m³ |
| Packaging sizes | 500 g; 5 kg |
| Storage conditions | 15–25 °C |
| Brand | Merck |
| Pack size | 500 g |